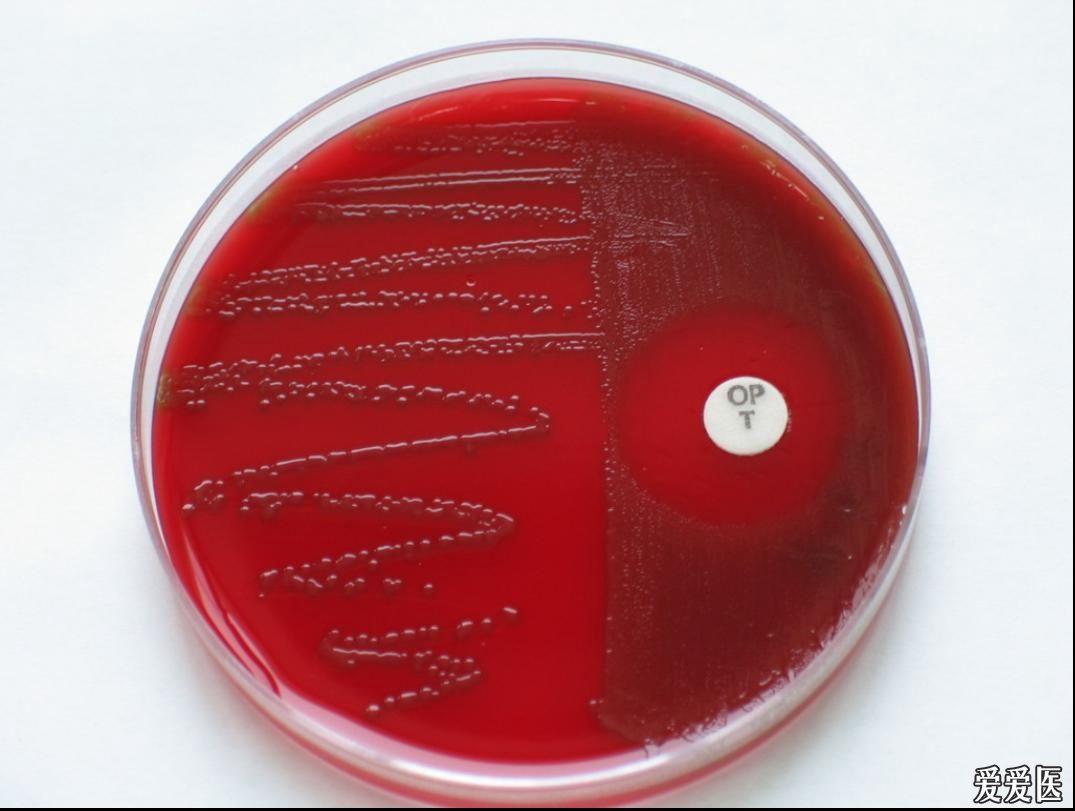
考考你的眼力8看图识菌肺炎链球菌

肺炎链球菌图

会造成人类肺炎的肺炎链球菌 streptococcus pneumoniae
图片尺寸550x309
肺炎球菌
图片尺寸1080x810
这样的肺炎链球菌,你见过吗?
图片尺寸1080x1134
这样的肺炎链球菌,你见过吗?
图片尺寸1080x1184
肺炎链球菌
图片尺寸1080x1439
肺炎链球菌
图片尺寸500x500
肺炎链球菌的细菌
图片尺寸1200x900
肺炎链球菌 (1)形态和染色:革兰染色阳性,菌体呈矛头状,成对排列,宽短
图片尺寸960x1280
第三十八讲肺炎链球菌全方位的博弈
图片尺寸1080x594
肺炎链球菌
图片尺寸1080x1439
肺炎双球菌(pneumococcus)又称肺炎链球菌,是菌体矛头状,常成双排列的
图片尺寸300x268
肺炎双球菌
图片尺寸272x264
考考你的眼力8--看图识菌-肺炎链球菌
图片尺寸1082x796
标准的肺炎链球菌
图片尺寸1080x1441
肺炎链球菌 (1)形态和染色:革兰染色阳性,菌体呈矛头状,成对排列,宽短
图片尺寸960x1280
肺炎链球菌:工作细胞中的"杀手"
图片尺寸620x411
考考你的眼力8看图识菌肺炎链球菌
图片尺寸1075x811
假肺炎链球菌与慢性阻塞性肺疾病的检验分享
图片尺寸650x488
肺炎链球菌(s. pneumoniae,图片来源于paramedicsworld.com)
图片尺寸510x384
肺炎链球菌荚膜
图片尺寸811x547